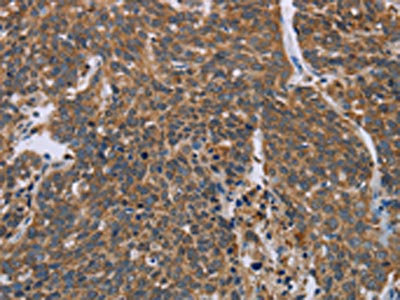

HIF1AN Antibody
-
中文名稱:HIF1AN兔多克隆抗體
-
貨號:CSB-PA447962
-
規格:¥1100
-
圖片:
-
The image on the left is immunohistochemistry of paraffin-embedded Human brain tissue using CSB-PA447962(HIF1AN Antibody) at dilution 1/25, on the right is treated with synthetic peptide. (Original magnification: ×200)
-
The image on the left is immunohistochemistry of paraffin-embedded Human cervical cancer tissue using CSB-PA447962(HIF1AN Antibody) at dilution 1/25, on the right is treated with synthetic peptide. (Original magnification: ×200)
-
Gel: 8%SDS-PAGE, Lysate: 40 μg, Lane: 231 cells, Primary antibody: CSB-PA447962(HIF1AN Antibody) at dilution 1/250, Secondary antibody: Goat anti rabbit IgG at 1/8000 dilution, Exposure time: 20 seconds
-
-
其他:
產品詳情
-
Uniprot No.:
-
基因名:HIF1AN
-
別名:DKFZp762F1811 antibody; Factor inhibiting HIF-1 antibody; Factor inhibiting HIF1 antibody; FIH 1 antibody; FIH-1 antibody; FIH1 antibody; FLJ20615 antibody; FLJ22027 antibody; HIF1AN antibody; HIF1N_HUMAN antibody; Hypoxia inducible factor 1 alpha inhibitor antibody; Hypoxia inducible factor 1 alpha subunit inhibitor antibody; Hypoxia inducible factor asparagine hydroxylase antibody; Hypoxia-inducible factor 1-alpha inhibitor antibody; Hypoxia-inducible factor asparagine hydroxylase antibody; Peptide aspartate beta dioxygenase antibody
-
宿主:Rabbit
-
反應種屬:Human,Mouse
-
免疫原:Synthetic peptide of Human HIF1AN
-
免疫原種屬:Homo sapiens (Human)
-
標記方式:Non-conjugated
-
抗體亞型:IgG
-
純化方式:Antigen affinity purification
-
濃度:It differs from different batches. Please contact us to confirm it.
-
保存緩沖液:-20°C, pH7.4 PBS, 0.05% NaN3, 40% Glycerol
-
產品提供形式:Liquid
-
應用范圍:ELISA,WB,IHC
-
推薦稀釋比:
Application Recommended Dilution ELISA 1:1000-1:2000 WB 1:500-1:2000 IHC 1:25-1:100 -
Protocols:
-
儲存條件:Upon receipt, store at -20°C or -80°C. Avoid repeated freeze.
-
貨期:Basically, we can dispatch the products out in 1-3 working days after receiving your orders. Delivery time maybe differs from different purchasing way or location, please kindly consult your local distributors for specific delivery time.
-
用途:For Research Use Only. Not for use in diagnostic or therapeutic procedures.
相關產品
靶點詳情
-
功能:Hydroxylates HIF-1 alpha at 'Asn-803' in the C-terminal transactivation domain (CAD). Functions as an oxygen sensor and, under normoxic conditions, the hydroxylation prevents interaction of HIF-1 with transcriptional coactivators including Cbp/p300-interacting transactivator. Involved in transcriptional repression through interaction with HIF1A, VHL and histone deacetylases. Hydroxylates specific Asn residues within ankyrin repeat domains (ARD) of NFKB1, NFKBIA, NOTCH1, ASB4, PPP1R12A and several other ARD-containing proteins. Also hydroxylates Asp and His residues within ARDs of ANK1 and TNKS2, respectively. Negatively regulates NOTCH1 activity, accelerating myogenic differentiation. Positively regulates ASB4 activity, promoting vascular differentiation.
-
基因功能參考文獻:
- Since the FIH-1 dependent hydroxylation of NAA10 occurs oxygen-dependently, NAA10 acetylates HIF-1alpha under normoxia but does not under hypoxia. PMID: 30237125
- Authors identified KANK3 as a new substrate for the oxygen sensor hypoxia-inducible factor 1-alpha inhibitor (HIF1AN), which hydroxylates HIF-1/2alpha and other ankyrin repeat domain-containing proteins at asparagine residues. PMID: 29047187
- MiR-31-5p plays an important role in HS formation by inhibiting FIH and regulating the HIF-1alpha pathway. PMID: 29056521
- Low FIH1 expression is associated with chemotherapy resistance in breast cancer. PMID: 28061479
- data support a model in which the facial triad carboxylate Asp(201) provides both steric and polar contacts to favor O2 access to the Fe(II) only after substrate binds, leading to coupled turnover in FIH and other alphaKG oxygenases. PMID: 27815979
- None of the clinicopathological parameters were associated with the expressions of FIH-1 and SOCS3 at mRNA level. PMID: 26749281
- This study provides novel clues indicating that miR-21, miR-31, and miR-184 co-target FIH tumor suppressor during pathogenesis in the vast majority of head and neck squamous cell carcinoma. PMID: 25351569
- Results suggest that NECAB3, a novel Mint3-binding protein, activates HIF-1 to promote normoxic glycolysis and tumorigenicity by forming a ternary complex with Mint3 and FIH-1. PMID: 26948053
- OTUB1 is a target for functional hydroxylation by FIH. PMID: 26752685
- demonstrates that miR-135b regulates ERalpha, AR and HIF1AN protein levels through interaction with their 3'UTR regions, and proliferation in ERalpha-positive BCa and AR-positive PCa cells PMID: 25907805
- Hypoxia, FIH inhibitors and mutation of asparagine 242 all potentiated TRPV3-mediated current, without altering TRPV3 protein levels, indicating that oxygen-dependent hydroxylation inhibits TRPV3 activity. PMID: 25413349
- the nuclear entry of FIH-1 depends on HIF-1alpha PMID: 25687434
- data support the concept that FIH-1 may interact with Notch2 and repress its activity, thereby playing a critical role in controlling the survival of vascular endothelial cells PMID: 25837583
- miR-31/FIH1 pathway associates with liver fibrosis, perhaps by participation in the TGF-beta/Smad3 signalling of hepatic stellate cells. PMID: 25728779
- FIH follows the consensus mechanism for alphaKG oxygenases, suggesting that FIH may be an ideal enzyme to directly access steps involved in O2 activation among the broad family of alphaKG oxygenases. PMID: 25423620
- The critical role of miR-31/FIH-1 nexus in colorectal cancer (CRC)was revealed and the contribution of miR-31 to CRC development by targeting FIH-1 was clarified. PMID: 24521875
- Data indicate that exosomal miR-135b directly suppressed its target factor-inhibiting hypoxia-inducible factor 1 (FIH-1) in endothelial cells. PMID: 25320245
- FIH-1 activity does not represent a major mechanism by which NP cells control HIF-1-dependent transcription, a testament to their adaptation to a unique hypoxic niche. PMID: 24867948
- The role of FIH-1 in regulating the transcriptional activity of HIF1A in glioblastoma multiforme. PMID: 24465898
- The role of FIH expression in high-risk locally advanced renal cell carcinoma (LARCC) was explored. PMID: 24388053
- Comparison of the structure of JMJD5 with that of FIH, a well characterized protein hydroxylase, reveals that human JMJD5 might function as a protein hydroxylase. PMID: 24100311
- FIH-1 depletion did lead to impaired binding of Par-3 to ASPP2. PMID: 23606740
- The stable Fe-OH2 bond plays an important part in FIH1's regulatory role over O2 homeostasis in humans and points toward a strategy for tightly coupling O2 activation with C-terminal transactivation domain of HIF-1alpha hydroxylation. PMID: 23351038
- Our results define a previously unknown mechanism for keratinocyte fate decisions where Notch signaling potential is, in part, controlled through a miR-31/FIH-1 nexus. PMID: 22891326
- Glycogen regulation in a HIF-1alpha-independent manner is a novel function for FIH-1 and provides new insight into how the corneal epithelium regulates its energy requirements. PMID: 22532441
- FIH activity is essential for tumor growth through the suppression of the p53-p21 axis, the major barrier that prevents cancer progression. PMID: 22002313
- FIH1 is expressed in the majority of invasive breast carcinomas and shows distinct subcellular localization patterns. PMID: 21732131
- Quantitative mass spectrometry reveals dynamics of factor-inhibiting hypoxia-inducible factor-catalyzed hydroxylation. PMID: 21808058
- The expression imbalance of HPH1 and FIH-1 in placenta may play an important role in the pathogenesis and development of severe pre-eclampsia through inhibiting HIF-1alpha. PMID: 19134330
- FIH does not uncouple O2 during turnover conditions, nor does it release reactive oxygen species under any tested conditions. PMID: 21443853
- Data report that histidinyl residues within the ankyrin repeat domain of tankyrase-2 can be hydroxylated by factor-inhibiting hypoxia-inducible factor. PMID: 21251231
- FIH also catalyzes the hydroxylation of highly conserved Asn residues within the ubiquitous ankyrin repeat domain (ARD)-containing proteins PMID: 21177872
- Bax-mediated apoptosis is suppressed by FIH1 overexpression, but accelerated by FIH1 deficiency. PMID: 21069436
- FIH1 appears to be a suppressor of oxygen-dependent genes in the kidney, operating through HIF-dependent and -independent mechanisms. PMID: 20720525
- Methylation-induced epigenetic silencing of FIH is unlikely to underlie up-regulated HIF-1alpha expression in human breast cancer but may play a role in other tumour types. PMID: 20727020
- miR-31 contributes to the development of head and neck squamous cell carcinoma by impeding FIH to activate HIF under normoxic conditions. PMID: 20145132
- Structural basis for recruitment of CBP/p300 by hypoxia-inducible factor-1 alpha PMID: 11959990
- FIH-1 is an asparaginyl hydroxylase enzyme that regulates the transcriptional activity of hypoxia-inducible factor PMID: 12080085
- present the structure of factor-inhibiting HIF-1 (FIH-1); describe the molecular details of the active site architecture mediating Fe(II) and 2-oxoglutarate binding PMID: 12432100
- FIH-1 has a unique active site pocket and interaction sites for HIF-1 and von Hippel-Lindau protein PMID: 12482756
- asparaginyl hydroxylase (FIH) catalytic properties in the oxygen sensing pathway are distinct from those of its prolyl 4-hydroxylases PMID: 14701857
- Molecular modeling of the HIF-1alpha CAD V802A in complex with FIH-1 predicted an alteration in asparagine positioning providing an explanation for the impaired catalysis, confirming the importance of Val-802 in asparaginyl hydroxylation by FIH-1. PMID: 14734545
- Human HIF asparaginyl hydroxylase, factor inhibiting HIF (FIH), also efficiently hydroxylates specific asparaginyl (Asn)-residues within proteins of the IkappaB family. PMID: 17003112
- ARD proteins function as natural inhibitors of FIH and that the hydroxylation status of these proteins provides another oxygen-dependent interface that modulates HIF signaling PMID: 17573339
- Data show that in renal cell carcinoma, the Cut-like homeodomain protein is involved in FIH-1 transcriptional regulation and is controlled by a specific signaling event involving protein kinase C zeta. PMID: 17682059
- FIH-1 is widely expressed in invasive breast carcinoma. The hypoxic response and survival suggests that tumour regulation of FIH-1 is an additional important mechanism for HIF pathway activation. PMID: 18096060
- These results suggest that Siah-1 might play a role as a regulator of FIH abundance under normoxic conditions. PMID: 18280659
- FIH-1 hydroxylates Notch ICD at two residues (N(1945) and N(2012)) that are critical for the function of Notch ICD as a transactivator within cells and during neurogenesis and myogenesis PMID: 18299578
- two enzyme-derived histidine ligands are sufficient for iron binding and catalysis by factor inhibiting HIF (FIH) PMID: 18611856
- Overexpression of the oxygen sensor FIH1 is associated with tumor aggressiveness in pancreatic endocrine tumors. PMID: 18927305
顯示更多
收起更多
-
亞細胞定位:Nucleus. Cytoplasm. Cytoplasm, perinuclear region. Note=Mainly cytoplasmic localization, but interaction with NOTCH1 results in nuclear localization and interaction with ABPA3 results in perinuclear localization in macrophages.
-
數據庫鏈接:
Most popular with customers
-
-
YWHAB Recombinant Monoclonal Antibody
Applications: ELISA, WB, IHC, IF, FC
Species Reactivity: Human, Mouse, Rat
-
-
-
-
-
-